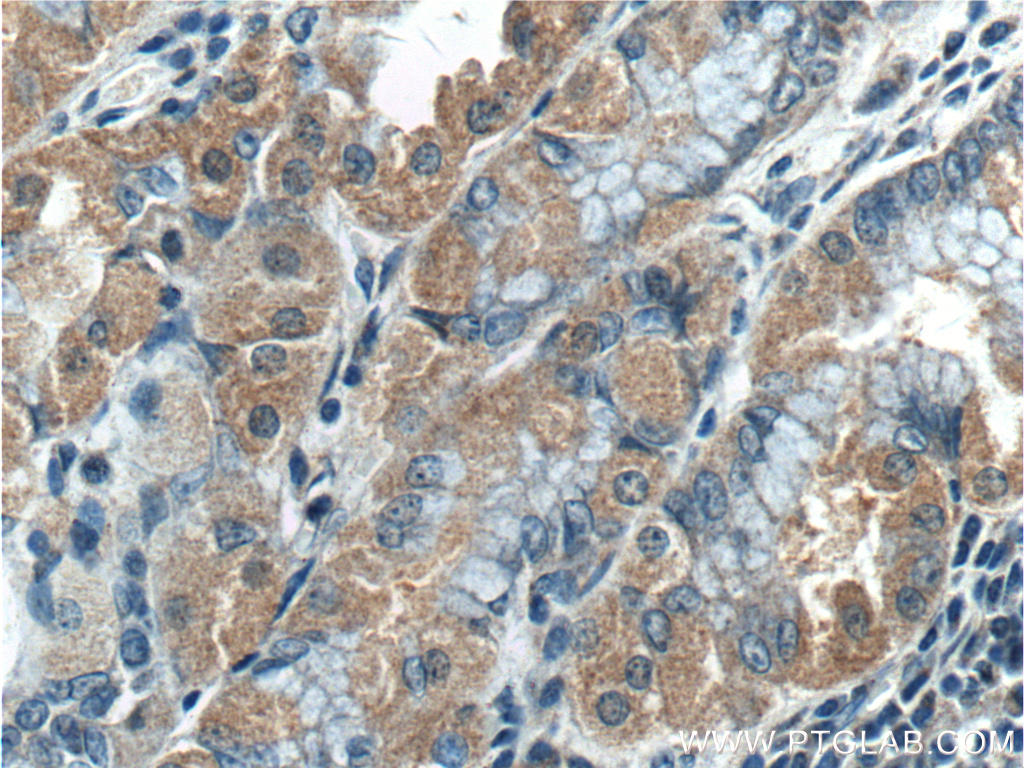

TBC1D24 抗体(anti TBC1D24 antibody)は、TBC1D24 タンパク質を検出するウサギポリクローナル抗体です。
[記入してもっとお得に!キャンペーン申込書]2点購入20%オフ専用申込書
または5点購入30%オフ専用申込書

[無料サンプル受付中!]GFP-Trap® 免疫沈降用アガロースビーズ標識GFP抗体 ![]()
[注目製品のご案内]シングルセル解析用オリゴヌクレオチド標識抗体『MultiPro™(マルチプロ)』
TBC1D24 抗体(anti TBC1D24 antibody)は、TBC1D24 タンパク質を検出するウサギポリクローナル抗体です。
[記入してもっとお得に!キャンペーン申込書]2点購入20%オフ専用申込書
または5点購入30%オフ専用申込書

[無料サンプル受付中!]GFP-Trap® 免疫沈降用アガロースビーズ標識GFP抗体 ![]()
[注目製品のご案内]シングルセル解析用オリゴヌクレオチド標識抗体『MultiPro™(マルチプロ)』
Proteintech Group, Inc.(プロテインテック)社は、2001年に設立された抗体製造メーカーです。現在までに、米国本社の他、英国、中国、ドイツ、フランス、シンガポール等で支社を展開し、各国で様々なマーカー抗体、タンパク質研究用試薬を供給しています。国内におけるテクニカルサポート等は、2016年より株式会社プロテインテック・ジャパン(www.ptglab.co.jp
)が担当しています。
プロテインテックは、引用数ランキング付き抗体検索サイトを運営する英国の「CiteAb
」が主催する「2025 CiteAb Awards」において「Researchers' choice(研究者の選択)
」部門および「Educational Resource of the Year(今年の教育リソース)
」部門の受賞者として選出されました。優れた品質と製品ラインアップに加え、カスタマーサービスや教育コンテンツが高く評価されています。
以下のリンクから、プロテインテックの主なカテゴリー製品をご覧いただけます。
| 商品名 | TBC1D24 抗体(Anti TBC1D24 antibody) |
|---|---|
| 品番 | 25254-1-AP |
| タイプ | ウサギポリクローナル |
| 交差種 | ヒト、マウス |
| アプリケーション | WB(ウェスタンブロット)、IHC(免疫組織化学)、ELISA |
| 標識 | 非標識 |
| 別名 | KIAA1171, TBC1 domain family member 24, TBC1 domain family, member 24, TBC1D24 |
| GeneID (遺伝子データベース情報) | 57465 |
| 抗原 | ヒト TBC1D24 組換えタンパク質(品番:Ag19380 |
| アイソタイプ | IgG |
| バッファー | PBS with 0.1% sodium azide and 50% glycerol pH 7.3. |
| 精製方法 | Antigen affinity purification |
| KD/KO 検証 | - |
| 保存方法 |
|

■ ポリクローナル抗体(20 UL包装の トライアルサイズ
あります。150 UL包装は国内在庫あり※)
| 品名 | メーカー | 品番 | 包装 | 希望販売価格 |
|---|---|---|---|---|
Anti TBC1D24, Trial Size: 20 UL, Human (Rabbit) Unlabeled![]() |
PGI | 25254-1-AP | 20 UL |
¥19,550(キャンペーン中) ¥23,000(通常希望販売価格) |
Anti TBC1D24, Human (Rabbit) Unlabeled![]() |
PGI | 25254-1-AP | 150 UL |
¥67,000 |
※ 国内在庫[あり/なし]の最新状況は、↑ 品名 クリック先ページ 当社在庫 の表示をご確認ください。タイミングによって[入荷予定あり/当社在庫なし]の場合があります。
■ モノクローナル抗体(20 UL包装の トライアルサイズ
あります。150 UL包装は国内在庫あり※)
| 品名 | メーカー | 品番 | 包装 | 希望販売価格 |
|---|---|---|---|---|
Anti TBC1D24, Trial Size: 20 UL, Human (Mouse) Unlabeled, 1C7C4![]() |
PGI | 68566-1-IG | 20 UL |
¥19,550(キャンペーン中) ¥23,000(通常希望販売価格) |
Anti TBC1D24, Human (Mouse) Unlabeled, 1C7C4![]() |
PGI | 68566-1-IG | 150 UL |
¥67,000 |
※ 国内在庫[あり/なし]の最新状況は、↑ 品名 クリック先ページ 当社在庫 の表示をご確認ください。タイミングによって[入荷予定あり/当社在庫なし]の場合があります。





商品は「研究用試薬」です。人や動物の医療用・臨床診断用・食品用としては使用しないように、十分ご注意ください。
※ 表示価格について
© COSMO BIO